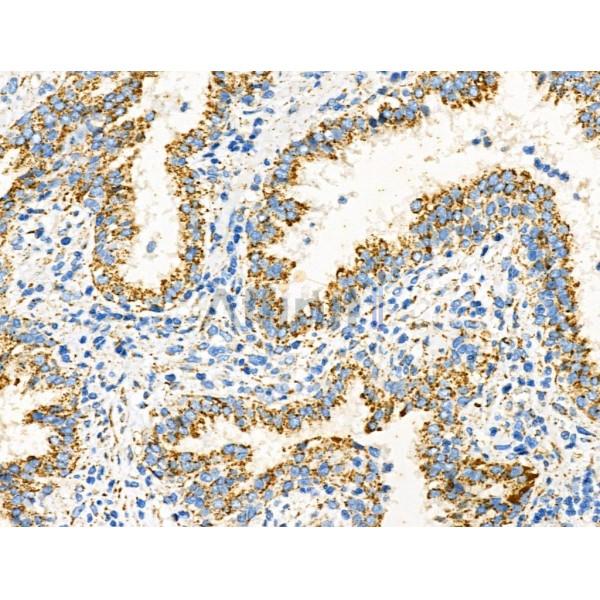
EpCAM Antibody - DF6311 at 1/100 staining Human prostate cancer by IHC-P.

EpCAM Antibody - #DF6311
| Product: | EpCAM Antibody |
| Catalog: | DF6311 |
| Description: | Rabbit polyclonal antibody to EpCAM |
| Application: | WB IHC IF/ICC |
| Cited expt.: | WB, IF/ICC |
| Reactivity: | Human, Mouse, Rat |
| Mol.Wt.: | 35kDa,40kDa; 35kD(Calculated). |
| Uniprot: | P16422 |
| RRID: | AB_2838277 |
Related Downloads
Protocols
Product Info
*The optimal dilutions should be determined by the end user. For optimal experimental results, antibody reuse is not recommended.
*Tips:
WB: For western blot detection of denatured protein samples. IHC: For immunohistochemical detection of paraffin sections (IHC-p) or frozen sections (IHC-f) of tissue samples. IF/ICC: For immunofluorescence detection of cell samples. ELISA(peptide): For ELISA detection of antigenic peptide.
Cite Format: Affinity Biosciences Cat# DF6311, RRID:AB_2838277.
Fold/Unfold
17 1A; 323/A3; Adenocarcinoma associated antigen; Adenocarcinoma-associated antigen; Antigen identified by monoclonal antibody AUA1; AUA1; CD326; CD326 antigen; Cell surface glycoprotein Trop 1; Cell surface glycoprotein Trop 2; Cell surface glycoprotein Trop-1; CO 17A; CO17 1A; CO17A; DIAR5; EGP 2; EGP; EGP2; EGP314; EGP40; Ep CAM; Ep-CAM; EPCAM; EPCAM_HUMAN; EpCAM1; Epithelial cell adhesion molecule; Epithelial Cell Adhesion Molecule Intracellular Domain (EpCAM-ICD); Epithelial cell surface antigen; Epithelial cellular adhesion molecule; Epithelial glycoprotein 1; Epithelial glycoprotein 314; Epithelial glycoprotein; ESA; GA733 1; GA733 2; GA733-2; gastrointestinal tumor-associated antigen 2, 35-KD glycoprotein; gp4; hEGP 2; hEGP314; HNPCC8; Human epithelial glycoprotein 2; KS 1/4 antigen; KS1/4; KSA; Ly74; Lymphocyte antigen 74; M1S 1; M1S2; M4S1; Major gastrointestinal tumor associated protein GA733 2; Major gastrointestinal tumor-associated protein GA733-2; mEGP314; Membrane component chromosome 4 surface marker (35kD glycoprotein); Membrane component, chromosome 4, surface marker 1; Membrane component, chromosome 4, surface marker; MIC18; MK 1; Protein 289A; TACD1; TACSTD1; TROP1; Tumor associated calcium signal transducer 1; Tumor associated calcium signal transducer 2 precursor; Tumor-associated calcium signal transducer 1;
Immunogens
A synthesized peptide derived from human EpCAM, corresponding to a region within the internal amino acids.
Highly and selectively expressed by undifferentiated rather than differentiated embryonic stem cells (ESC). Levels rapidly diminish as soon as ESC's differentiate (at protein levels). Expressed in almost all epithelial cell membranes but not on mesodermal or neural cell membranes. Found on the surface of adenocarcinoma.
- P16422 EPCAM_HUMAN:
- Protein BLAST With
- NCBI/
- ExPASy/
- Uniprot
MAPPQVLAFGLLLAAATATFAAAQEECVCENYKLAVNCFVNNNRQCQCTSVGAQNTVICSKLAAKCLVMKAEMNGSKLGRRAKPEGALQNNDGLYDPDCDESGLFKAKQCNGTSMCWCVNTAGVRRTDKDTEITCSERVRTYWIIIELKHKAREKPYDSKSLRTALQKEITTRYQLDPKFITSILYENNVITIDLVQNSSQKTQNDVDIADVAYYFEKDVKGESLFHSKKMDLTVNGEQLDLDPGQTLIYYVDEKAPEFSMQGLKAGVIAVIVVVVIAVVAGIVVLVISRKKRMAKYEKAEIKEMGEMHRELNA
Research Backgrounds
May act as a physical homophilic interaction molecule between intestinal epithelial cells (IECs) and intraepithelial lymphocytes (IELs) at the mucosal epithelium for providing immunological barrier as a first line of defense against mucosal infection. Plays a role in embryonic stem cells proliferation and differentiation. Up-regulates the expression of FABP5, MYC and cyclins A and E.
Hyperglycosylated in carcinoma tissue as compared with autologous normal epithelia. Glycosylation at Asn-198 is crucial for protein stability.
Lateral cell membrane>Single-pass type I membrane protein. Cell junction>Tight junction.
Note: Colocalizes with CLDN7 at the lateral cell membrane and tight junction.
Highly and selectively expressed by undifferentiated rather than differentiated embryonic stem cells (ESC). Levels rapidly diminish as soon as ESC's differentiate (at protein levels). Expressed in almost all epithelial cell membranes but not on mesodermal or neural cell membranes. Found on the surface of adenocarcinoma.
Belongs to the EPCAM family.
References
Application: IF/ICC Species: human Sample: hLECs
Application: WB Species: rat Sample: exosomes
Restrictive clause
Affinity Biosciences tests all products strictly. Citations are provided as a resource for additional applications that have not been validated by Affinity Biosciences. Please choose the appropriate format for each application and consult Materials and Methods sections for additional details about the use of any product in these publications.
For Research Use Only.
Not for use in diagnostic or therapeutic procedures. Not for resale. Not for distribution without written consent. Affinity Biosciences will not be held responsible for patent infringement or other violations that may occur with the use of our products. Affinity Biosciences, Affinity Biosciences Logo and all other trademarks are the property of Affinity Biosciences LTD.